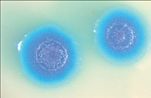

Γεννήθηκε το πρώτο ον στον πλανήτη που μπορεί να αναπαράγεται και έχει για μπαμπά έναν…υπολογιστή!
ΤΕΧΝΗΤΗ ΖΩΗ ΣΤΟ ΕΡΓΑΣΤΗΡΙΟ
Γεννήθηκε το πρώτο ον στον πλανήτη που μπορεί να αναπαράγεται και έχει για μπαμπά έναν...υπολογιστή!
Γεννήθηκε το πρώτο ον στον πλανήτη που μπορεί να αναπαράγεται και έχει για μπαμπά έναν...υπολογιστή!
Ακολούθησε το Βήμα στο Google news και μάθε όλες τις τελευταίες ειδήσεις.


